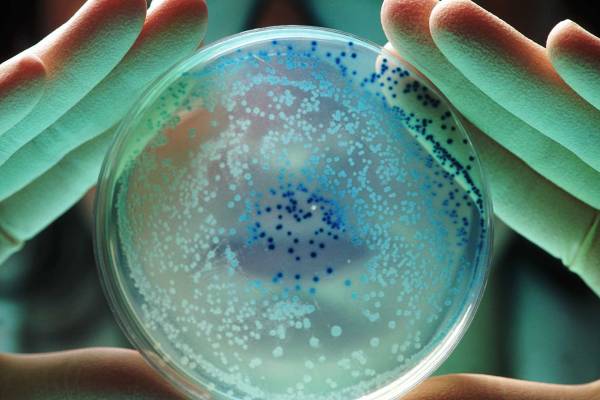
Escherichia coli: o que você precisa saber sobre essa bactéria

Gestação
Saúde
O que é descolamento de placenta? E quais os riscos?
Influenciadora digital Viih Tube foi diagnosticada recentemente após um sangramento vaginal; complicação causa risco à vida da mãe e do bebê
fertilidadeComo saber se estou ovulando? O corpo dá alguns sinais?
Para ler ou assistir
nome de bebe
Sem erro: 7 dicas para escolher o nome do bebê sem arrependimento
Está em dúvida sobre um nome ou os motivos para dá-lo a uma criança? Essas sugestões podem ser úteis para ajudar a resolver a questão
Desenvolvimento infantil10 livros para ler com as crianças de diferentes faixas etárias e gostos
Guia de pais
Educação positiva
Como lidar com 6 comportamentos desafiadores da criança
Conversamos com especialistas para exemplificar casos corriqueiros na rotina com os filhos e oferecer caminhos para pais e cuidadores, da teoria à prática
dever de todos